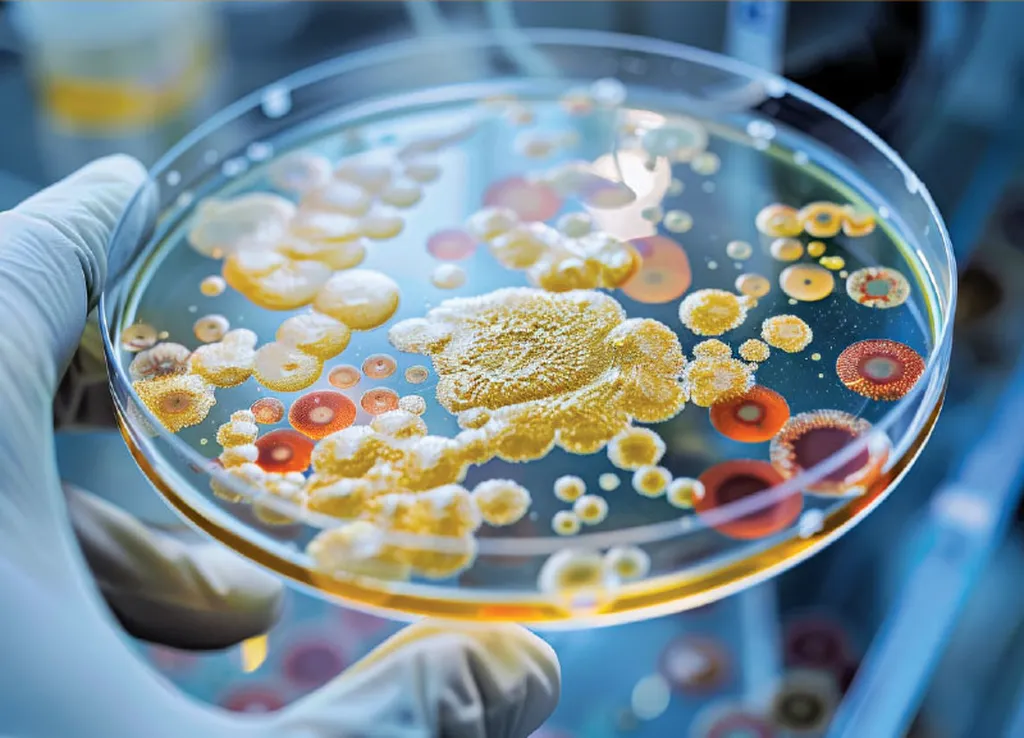

China’s No-Tillage Farming Revolution: A Drought Solution for Black Soil Regions
In the vast black soil (Mollisols) region of Northeast China, farmers are facing an increasingly pressing challenge: waterlogging. As extreme rainfall events become more frequent, crops are suffering from aeration stress, and traditional farming prac
China’s No-Tillage Farming Revolution: A Drought Solution for Black Soil Regions Read More »